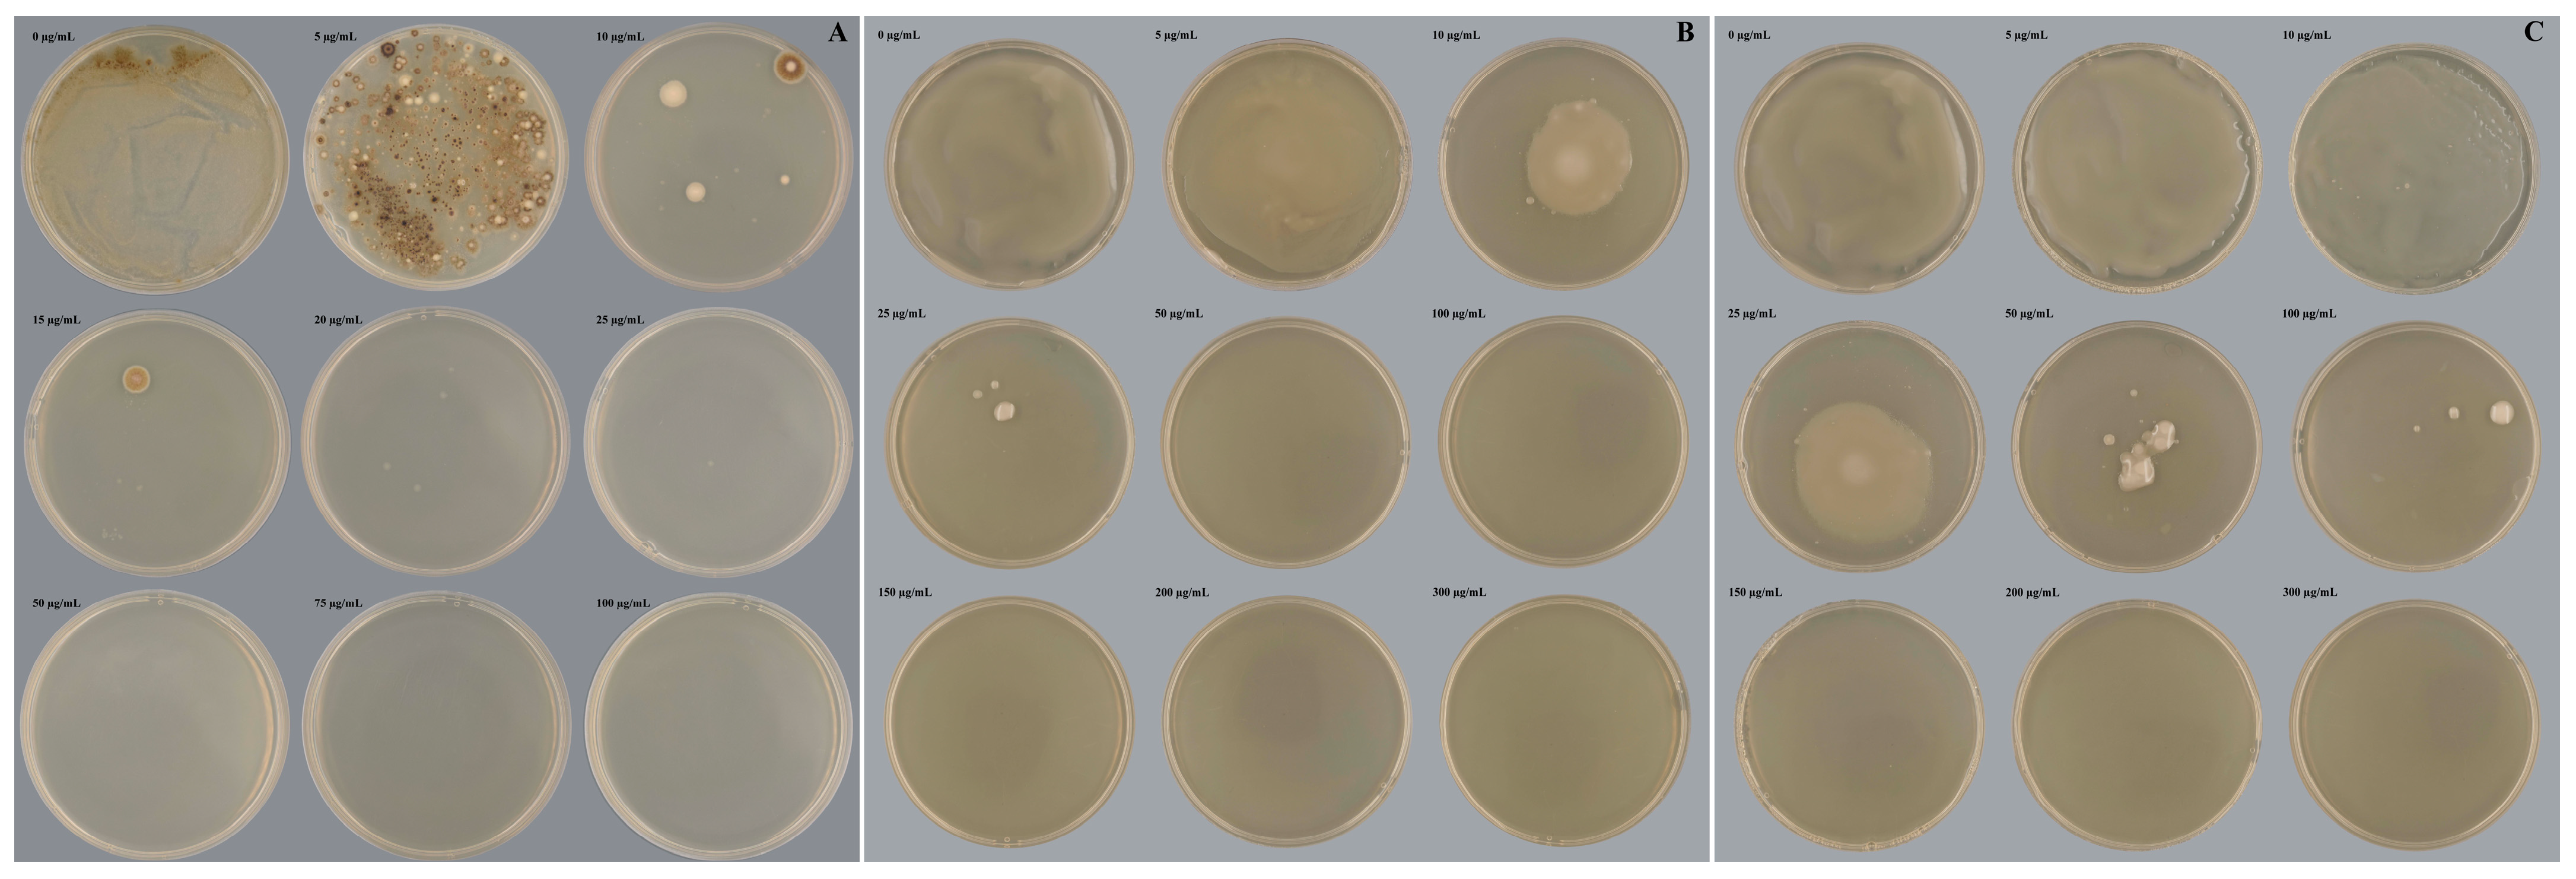
Ijms 24 13009 g001
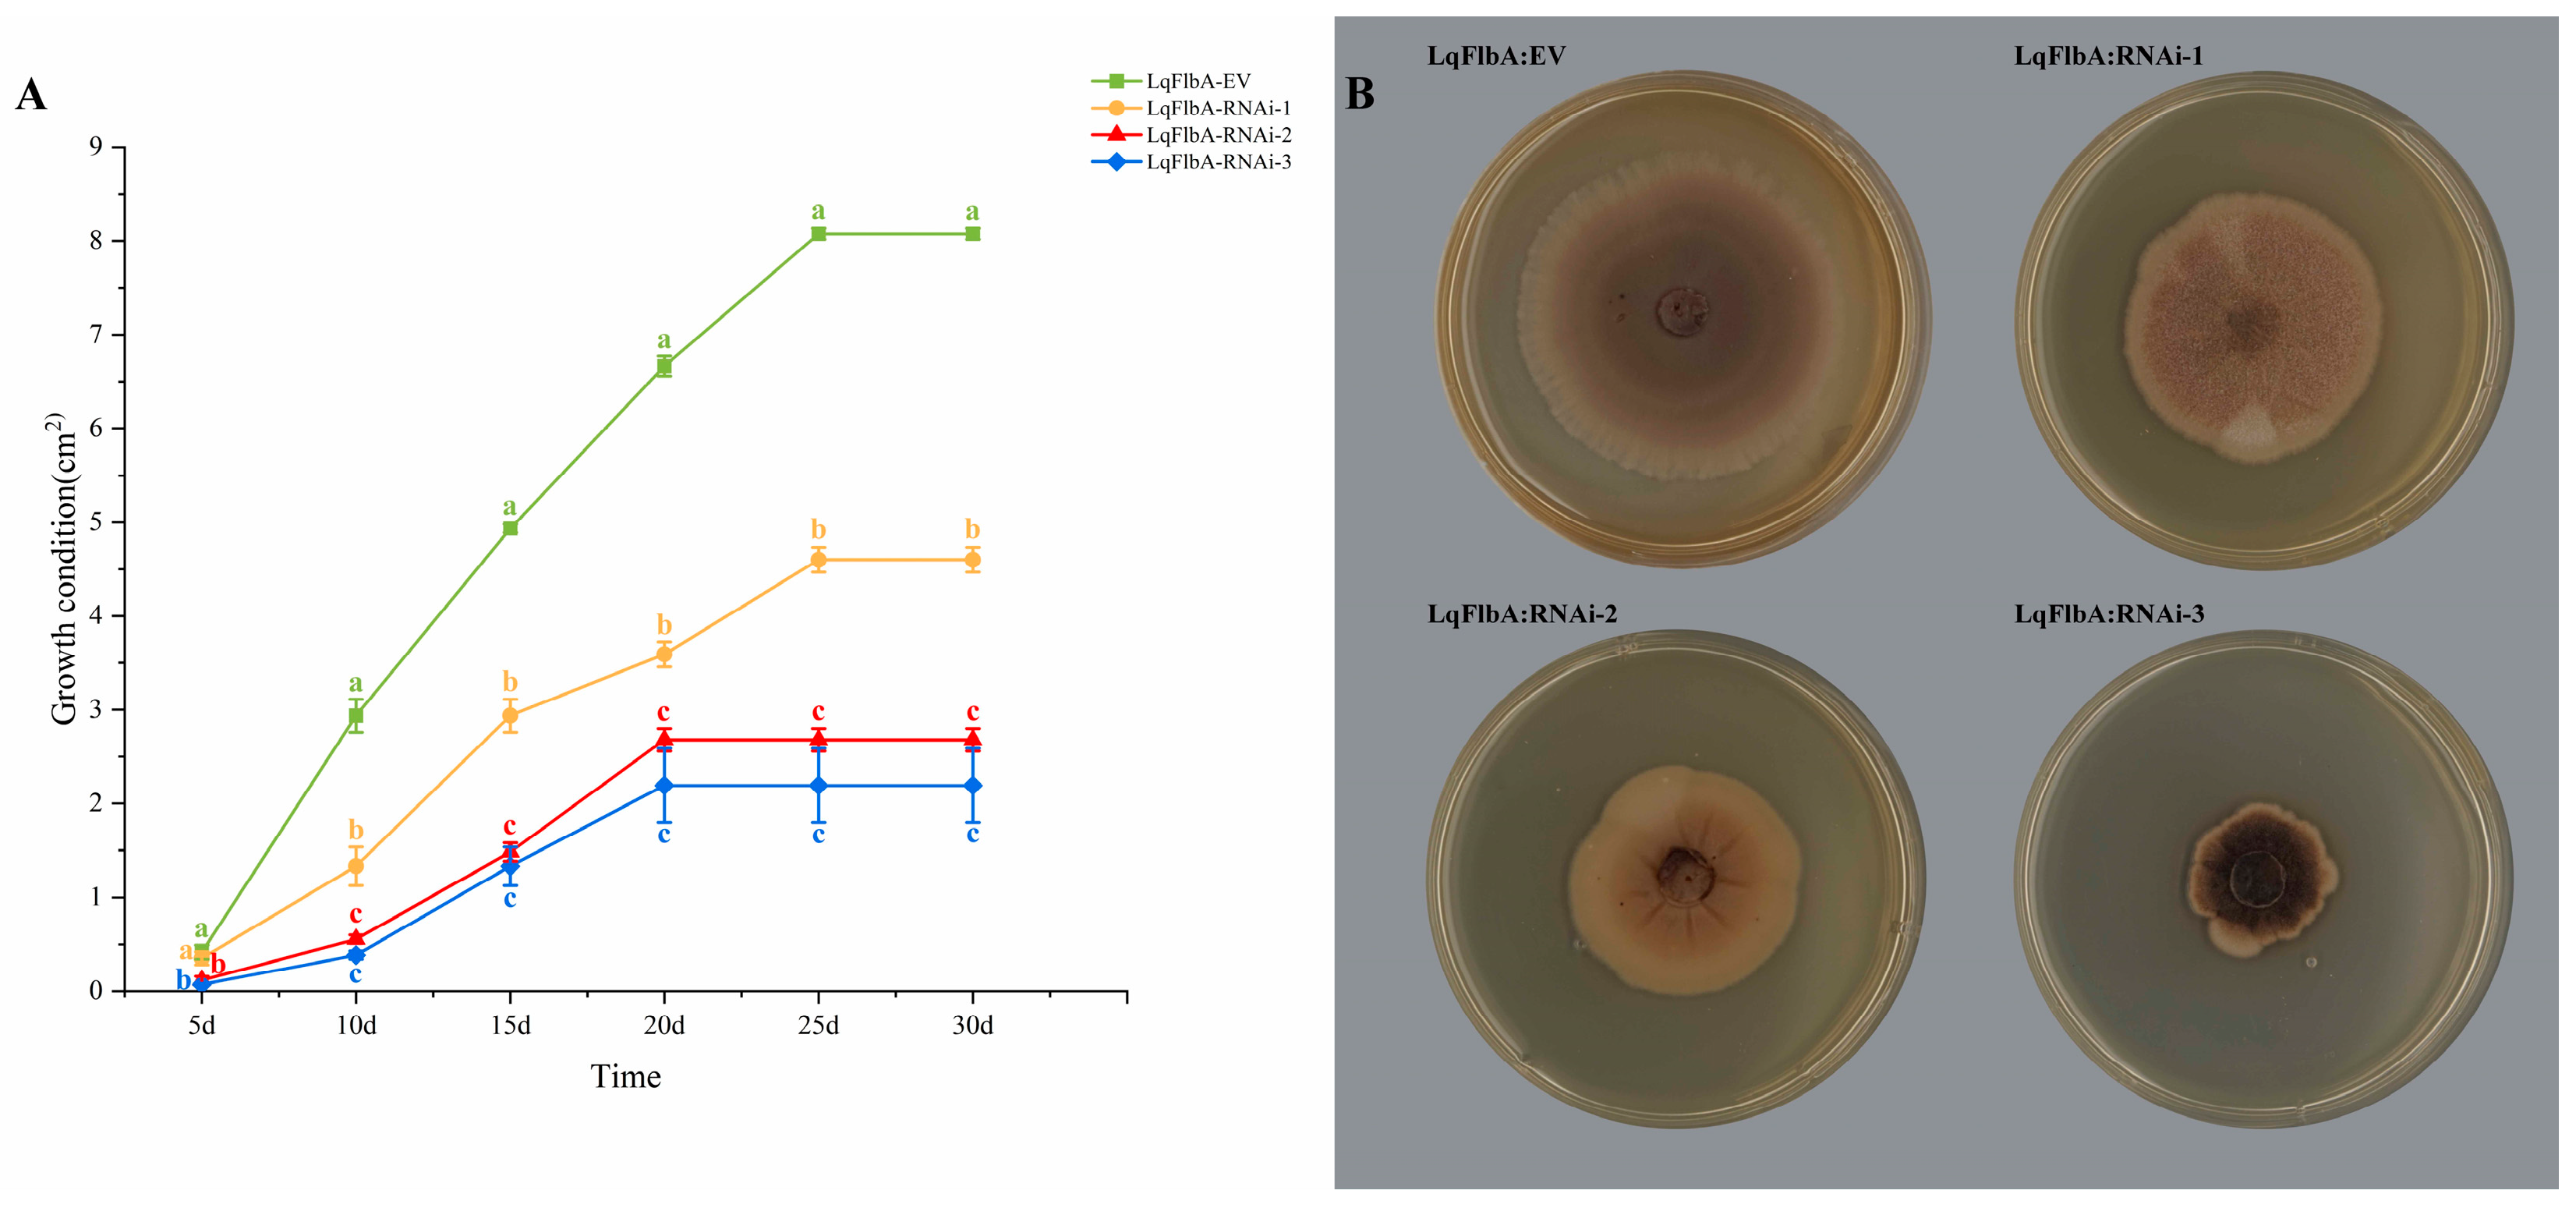
Ijms 24 13009 g004

Establishment of RNA Interference Genetic Transformation System and Functional Analysis of FlbA Gene in Leptographium qinlingensis
Abstract
:1. Introduction
2. Results
2.1. Antibiotic Sensitivity of Experimental Strains
2.2. ATMT of L. qinlingensis
2.3. Confirmation of Transformants
2.4. LqFlbA Is Required for the Growth and Reproduction of L. qinlingensis
2.5. Knockdown of LqFlbA Results in Diminished Pathogenicity of L. qinlingensis
3. Discussion
4. Materials and Methods
4.1. Strains, Plasmids, and Media
4.2. Construction of Silencing Vectors
4.3. Antibiotic Sensitivity of Experimental Strains
4.4. A. tumefaciens-Mediated Transformation (ATMT)
4.5. Confirmation of Transformants
4.6. Optimization of Transformation Parameters
4.7. Growth and Pathogenicity Assay of Transformants
4.8. Statistical Analysis
Author Contributions
Funding
Institutional Review Board Statement
Informed Consent Statement
Data Availability Statement
Acknowledgments
Conflicts of Interest
References
- Li, X.J.; Gao, J.M.; Chen, H.; Zhang, A.L.; Tang, M. Toxins from a symbiotic fungus, Leptographium qinlingensis associated with Dendroctonus armandi and their in vitro toxicities to Pinus armandi seedlings. Eur. J. Plant Pathol. 2012, 134, 239–247. [Google Scholar] [CrossRef]
- Chen, W.Y.; Fan, X.L.; Tian, C.M.; Li, F.; Chou, G.F. Identification and characterization of Neocosmospora silvicola causing canker disease on Pinus armandii in China. Plant Dis. 2023. [Google Scholar] [CrossRef] [PubMed]
- Chen, H.; Tang, M. Spatial and temporal dynamics of bark beetles in Chinese white pine in Qinling Mountains of Shaanxi province, China. Environ. Entomol. 2014, 36, 1124–1130. [Google Scholar] [CrossRef]
- Gan, T.; An, H.L.; Tang, M.; Chen, H. Phylogeny of regulators of G-protein signaling genes in Leptographium qinlingensis and expression levels of three RGSs in response to different terpenoids. Microorganisms 2022, 10, 1698. [Google Scholar] [CrossRef]
- Wang, H.; Wang, T.; Liu, Y.; Zeng, F.; Zhang, H.; Decock, C.; Zhang, X.; Lu, Q. Diversity of Ophiostomatoid fungi associated with Dendroctonus armandi infesting Pinus armandii in western China. J. Fungi 2022, 8, 214. [Google Scholar] [CrossRef] [PubMed]
- Hu, X.; Wang, C.Y.; Wang, L.; Zhang, R.R.; Chen, H. Influence of temperature, pH and metal ions on guaiacol oxidation of purified laccase from Leptographium qinlingensis. World J. Microbiol. Biotechnol. 2014, 30, 1285–1290. [Google Scholar] [CrossRef]
- Bracewell, R.R.; Six, D.L. Broadscale specificity in a bark beetle–fungal symbiosis: A spatio-temporal analysis of the mycangial fungi of the western pine beetle. Microb. Ecol. 2014, 68, 859–870. [Google Scholar] [CrossRef]
- Dai, L.L.; Li, H.; Zheng, J.; Chen, H. Transcriptome analyses of the Chinese white pine beetle-fungal symbiont Leptographium qinlingensis under terpene stress or growth on host pine sawdust. Symbiosis 2022, 86, 17–31. [Google Scholar] [CrossRef]
- Dohet, L.; Grégoire, J.C.; Berasategui, A.; Kaltenpoth, M.; Biedermann, P.H. Bacterial and fungal symbionts of parasitic Dendroctonus bark beetles. FEMS Microbiol. Ecol. 2016, 92, fiw129. [Google Scholar] [CrossRef]
- Lehenberger, M.; Foh, N.; Göttlein, A.; Six, D.; Biedermann, P.H.W. Nutrient-poor breeding substrates of ambrosia beetles are enriched with biologically important elements. Front. Microbiol. 2021, 12, 664542. [Google Scholar] [CrossRef]
- Six, D.L. Niche construction theory can link bark beetle-fungus symbiosis type and colonization behavior to large scale causal chain-effects. Curr. Opin. Insect Sci. 2020, 39, 27–34. [Google Scholar] [CrossRef] [PubMed]
- Six, D.L.; Elser, J.J. Mutualism is not restricted to tree-killing bark beetles and fungi: The ecological stoichiometry of secondary bark beetles, fungi, and a scavenger. Ecol. Entomol. 2020, 45, 1134–1145. [Google Scholar] [CrossRef]
- Dai, L.L.; Zheng, J.; Ye, J.Q.; Chen, H. Phylogeny of Leptographium qinlingensis cytochrome P450 genes and transcription levels of six CYPs in response to different nutrition media or terpenoids. Arch. Microbiol. 2021, 204, 16. [Google Scholar] [CrossRef] [PubMed]
- Dai, L.L.; Li, Z.M.; Yu, J.M.; Ma, M.Y.; Zhang, R.R.; Chen, H.; Pham, T. The CYP51F1 gene of Leptographium qinlingensis: Sequence characteristic, phylogeny and transcript levels. Int. J. Mol. Sci. 2015, 16, 12014–12034. [Google Scholar] [CrossRef]
- An, H.L.; Gan, T.; Tang, M.; Chen, H. Molecular mechanism of overcoming host resistance by the target of rapamycin gene in Leptographium qinlingensis. Microorganisms 2022, 10, 503. [Google Scholar] [CrossRef]
- Shafran, H.; Miyara, I.; Eshed, R.; Prusky, D.; Sherman, A. Development of new tools for studying gene function in fungi based on the Gateway system. Fungal Genet. Biol. 2008, 45, 1147–1154. [Google Scholar] [CrossRef]
- McDonald, T.; Brown, D.; Keller, N.P.; Hammond, T.M. RNA silencing of mycotoxin production in Aspergillus and Fusarium species. Mol. Plant Microbe Interact. 2005, 18, 539–545. [Google Scholar] [CrossRef]
- Nakayashiki, H. RNA silencing in fungi: Mechanisms and applications. FEBS Lett. 2005, 579, 5950–5957. [Google Scholar] [CrossRef]
- Jeon, J.; Park, S.Y.; Chi, M.H.; Choi, J.; Park, J.; Rho, H.S.; Kim, S.; Goh, J.; Yoo, S.; Choi, J.; et al. Genome-wide functional analysis of pathogenicity genes in the rice blast fungus. Nat. Genet. 2007, 39, 561–565. [Google Scholar] [CrossRef]
- Bolton, M.D.; van Esse, H.P.; Vossen, J.H.; de Jonge, R.; Stergiopoulos, I.; Stulemeijer, I.J.; van den Berg, G.C.; Borrás-Hidalgo, O.; Dekker, H.L.; de Koster, C.G.; et al. The novel Cladosporium fulvum lysin motif effector Ecp6 is a virulence factor with orthologues in other fungal species. Mol. Microbiol. 2008, 69, 119–136. [Google Scholar] [CrossRef]
- Van Esse, H.P.; Van’t Klooster, J.W.; Bolton, M.D.; Yadeta, K.A.; Van Baarlen, P.; Boeren, S.; Vervoort, J.; de Wit, P.J.; Thomma, B.P. The Cladosporium fulvum virulence protein Avr2 inhibits host proteases required for basal defense. Plant Cell 2008, 20, 1948–1963. [Google Scholar] [CrossRef]
- Carneiro, J.S.; de la Bastide, P.Y.; Chabot, M.; Lerch, L.; Hintz, W.E. Suppression of polygalacturonase gene expression in the phytopathogenic fungus Ophiostoma novo-ulmi by RNA interference. Fungal Genet. Biol. 2010, 47, 399–405. [Google Scholar] [CrossRef]
- Kück, U.; Hoff, B. New tools for the genetic manipulation of filamentous fungi. Appl. Microbiol. Biotechnol. 2010, 86, 51–62. [Google Scholar] [CrossRef] [PubMed]
- Dong, Y.H.; Wang, S.T. Agrobacterium tumefaciens-mediated transformation method for Fusarium oxysporum. In Fusarium Wilt: Methods and Protocols; Coleman, J., Ed.; Springer: New York, NY, USA, 2022; Volume 2391, pp. 63–73. [Google Scholar]
- Michielse, C.B.; Hooykaas, P.J.; van den Hondel, C.A.; Ram, A.F. Agrobacterium-mediated transformation as a tool for functional genomics in fungi. Curr. Genet. 2005, 48, 1–17. [Google Scholar] [CrossRef] [PubMed]
- Thai, H.D.; Nguyen, B.T.; Nguyen, V.M.; Nguyen, Q.H.; Tran, V.T. Development of a new Agrobacterium-mediated transformation system based on a dual auxotrophic approach in the filamentous fungus Aspergillus oryzae. World J. Microbiol. Biotechnol. 2021, 37, 92. [Google Scholar] [CrossRef]
- Thai, H.D.; Do, L.; Nguyen, X.T.; Vu, T.X.; Tran, H.T.T.; Nguyen, H.Q.; Tran, V.T. A newly constructed Agrobacterium-mediated transformation system based on the hisB auxotrophic marker for genetic manipulation in Aspergillus niger. Arch. Microbiol. 2023, 205, 183. [Google Scholar] [CrossRef] [PubMed]
- Lengeler, K.B.; Davidson, R.C.; D’Souza, C.; Harashima, T.; Shen, W.C.; Wang, P.; Pan, X.; Waugh, M.; Heitman, J. Signal transduction cascades regulating fungal development and virulence. Microbiol. Mol. Biol. Rev. 2000, 64, 746–785. [Google Scholar] [CrossRef]
- Neves, S.R.; Ram, P.T.; Iyengar, R. G protein pathways. Science 2002, 296, 1636–1639. [Google Scholar] [CrossRef] [PubMed]
- Yu, J.H. Heterotrimeric G protein signaling and RGSs in Aspergillus nidulans. J. Microbiol. 2006, 44, 145–154. [Google Scholar]
- Zhang, H.F.; Tang, W.; Liu, K.Y.; Huang, Q.; Zhang, X.; Yan, X.; Chen, Y.; Wang, J.S.; Qi, Z.Q.; Wang, Z.Y.; et al. Eight RGS and RGS-like proteins orchestrate growth, differentiation, and pathogenicity of Magnaporthe oryzae. PLoS Pathog. 2011, 7, e1002450. [Google Scholar] [CrossRef]
- Shin, K.S.; Park, H.S.; Kim, Y.H.; Yu, J.H. Comparative proteomic analyses reveal that FlbA down-regulates gliT expression and SOD activity in Aspergillus fumigatus. J. Proteom. 2013, 87, 40–52. [Google Scholar] [CrossRef]
- Han, K.-H.; Seo, J.-A.; Yu, J.-H. Regulators of G-protein signalling in Aspergillus nidulans: RgsA downregulates stress response and stimulates asexual sporulation through attenuation of GanB (Gα) signalling. Mol. Microbiol. 2004, 53, 529–540. [Google Scholar] [CrossRef] [PubMed]
- Park, H.-S.; Kim, M.-J.; Yu, J.-H.; Shin, K.-S. Heterotrimeric G-protein signalers and RGSs in Aspergillus fumigatus. Pathogens 2020, 9, 902. [Google Scholar] [CrossRef]
- Xie, R.; Yang, K.; Tumukunde, E.; Guo, Z.; Zhang, B.; Liu, Y.; Zhuang, Z.; Yuan, J.; Wang, S.; Buan, N.R. Regulator of G protein signaling contributes to the development and aflatoxin biosynthesis in Aspergillus flavus through the regulation of Gα activity. Appl. Environ. Microbiol. 2022, 88, e00244-22. [Google Scholar] [CrossRef] [PubMed]
- Lee, B.N.; Adams, T.H. Overexpression of flbA, an early regulator of Aspergillus asexual sporulation, leads to activation of brlA and premature initiation of development. Mol. Microbiol. 1994, 14, 323–334. [Google Scholar] [CrossRef]
- Yan, H.J.; Zhou, Z.H.; Shim, W.B. Two regulators of G-protein signaling (RGS) proteins FlbA1 and FlbA2 differentially regulate fumonisin B1 biosynthesis in Fusarium verticillioides. Curr. Genet. 2021, 67, 305–315. [Google Scholar] [CrossRef] [PubMed]
- Weld, R.J.; Plummer, K.M.; Carpenter, M.A.; Ridgway, H.J. Approaches to functional genomics in filamentous fungi. Cell Res. 2006, 16, 31–44. [Google Scholar] [CrossRef]
- Frandsen, R.J. A guide to binary vectors and strategies for targeted genome modification in fungi using Agrobacterium tumefaciens-mediated transformation. J. Microbiol. Methods 2011, 87, 247–262. [Google Scholar] [CrossRef]
- Arenz, C.; Schepers, U. RNA interference: From an ancient mechanism to a state of the art therapeutic application? Naturwissenschaften 2003, 90, 345–359. [Google Scholar] [CrossRef]
- Cheng, P.; He, Q.; He, Q.; Wang, L.; Liu, Y. Regulation of the Neurospora circadian clock by an RNA helicase. Genes Dev. 2005, 19, 234–241. [Google Scholar] [CrossRef]
- Huang, E.X.; Zhang, Y.; Sun, L.; Zhu, Y.R.; Tang, S.Y.; Mo, C.H.; Zhao, B.Y.; Lu, H. Swnk plays an important role in the biosynthesis of swainsonine in Metarhizium anisopliae. Biotechnol. Lett. 2023, 45, 509–519. [Google Scholar] [CrossRef]
- Flores-Alvarez, L.J.; Corrales-Escobosa, A.R.; Cortés-Penagos, C.; Martínez-Pacheco, M.; Wrobel-Zasada, K.; Wrobel-Kaczmarczyk, K.; Cervantes, C.; Gutiérrez-Corona, F. The Neurospora crassa chr-1 gene is up-regulated by chromate and its encoded CHR-1 protein causes chromate sensitivity and chromium accumulation. Curr. Genet. 2012, 58, 281–290. [Google Scholar] [CrossRef] [PubMed]
- Scindiya, M.; Malathi, P.; Kaverinathan, K.; Ramesh Sundar, A.; Viswanathan, R. RNA-mediated silencing of PKS1 gene in Colletotrichum falcatum causing red rot in sugarcane. Eur. J. Plant Pathol. 2019, 153, 371–384. [Google Scholar] [CrossRef]
- Scindiya, M.; Malathi, P.; Kaverinathan, K.; Sundar, A.R.; Viswanathan, R. Knock-down of glucose transporter and sucrose non-fermenting gene in the hemibiotrophic fungus Colletotrichum falcatum causing sugarcane red rot. Mol. Biol. Rep. 2021, 48, 2053–2061. [Google Scholar] [CrossRef]
- Bundock, P.; den Dulk-Ras, A.; Beijersbergen, A.; Hooykaas, P.J. Trans-kingdom T-DNA transfer from Agrobacterium tumefaciens to Saccharomyces cerevisiae. EMBO J. 1995, 14, 3206–3214. [Google Scholar] [CrossRef]
- De Groot, M.J.A.; Bundock, P.; Hooykaas, P.J.J.; Beijersbergen, A.G.M. Agrobacterium tumefaciens-mediated transformation of filamentous fungi. Nat. Biotechnol. 1998, 16, 839–842. [Google Scholar] [CrossRef] [PubMed]
- Meyer, V.; Mueller, D.; Strowig, T.; Stahl, U. Comparison of different transformation methods for Aspergillus giganteus. Curr. Genet. 2003, 43, 371–377. [Google Scholar] [CrossRef]
- Sugui, J.A.; Chang, Y.C.; Kwon-Chung, K.J. Agrobacterium tumefaciens-mediated transformation of Aspergillus fumigatus: An efficient tool for insertional mutagenesis and targeted gene disruption. Appl. Environ. Microbiol. 2005, 71, 1798–1802. [Google Scholar] [CrossRef]
- Michielse, C.B.; Hooykaas, P.J.; Van den Hondel, C.A.; Ram, A.F. Agrobacterium-mediated transformation of the filamentous fungus Aspergillus awamori. Nat. Protoc. 2008, 3, 1671–1678. [Google Scholar] [CrossRef] [PubMed]
- Wang, Y.; DiGuistini, S.; Wang, T.C.; Bohlmann, J.; Breuil, C. Agrobacterium-meditated gene disruption using split-marker in Grosmannia clavigera, a mountain pine beetle associated pathogen. Curr. Genet. 2010, 56, 297–307. [Google Scholar] [CrossRef]
- Hu, Y.F.; Zheng, Y.F.; Liu, B.X.; Gong, Y.X.; Shao, Y.C. Mrhst4 gene, coding for NAD(+)-dependent deacetylase is involved in citrinin production of Monascus ruber. J. Appl. Microbol. 2023, 134, lxad042. [Google Scholar] [CrossRef]
- Zhang, J.T.; Han, X.G.; Su, Y.; Staehelin, C.; Xu, C.C. T-DNA insertion mutagenesis in Penicillium brocae results in identification of an enolase gene mutant impaired in secretion of organic acids and phosphate solubilization. Microbiology 2023, 169, 001325. [Google Scholar] [CrossRef]
- Idnurm, A.; Bailey, A.M.; Cairns, T.C.; Elliott, C.E.; Foster, G.D.; Ianiri, G.; Jeon, J. A silver bullet in a golden age of functional genomics: The impact of Agrobacterium-mediated transformation of fungi. Fungal Biol. Biotechnol. 2017, 4, 6. [Google Scholar] [CrossRef] [PubMed]
- Li, D.D.; Tang, Y.; Lin, J.; Cai, W.W. Methods for genetic transformation of filamentous fungi. Microb. Cell Factories 2017, 16, 168–180. [Google Scholar] [CrossRef] [PubMed]
- Tanguay, P.; Coupal, J.; Bernier, L. Genetic transformation, electrophoretic karyotyping and isolation of insertional mutants in the tree pathogenic fungus Neonectria galligena. For. Pathol. 2003, 33, 413–428. [Google Scholar] [CrossRef]
- Tanguay, P.; Breuil, C. Transforming the sapstaining fungus Ophiostoma piceae with Agrobacterium tumefaciens. Can. J. Microbiol. 2003, 49, 301–304. [Google Scholar] [CrossRef] [PubMed]
- Royer, J.C.; Dewar, K.; Hubbes, M.; Horgen, P.A. Analysis of a high frequency transformation system for Ophiostoma ulmi, the causal agent of Dutch elm disease. Mol. Gen. Genet. MGG 1991, 225, 168–176. [Google Scholar] [CrossRef]
- Hu, Y.; Dai, Q.Q.; Liu, Y.Y.; Yang, Z.; Song, N.; Gao, X.N.; Voegele, R.T.; Kang, Z.S.; Huang, L.L. Agrobacterium tumefaciens-mediated transformation of the causative agent of valsa canker of apple tree Valsa mali var. mali. Curr. Microbiol. 2014, 68, 769–776. [Google Scholar] [CrossRef]
- Foster, A.J.; Morency, M.J.; Séguin, A.; Tanguay, P. Agrobacterium tumefaciens-mediated transformation for targeted disruption and over expression of genes in the poplar pathogen Sphaerulina musiva. For. Pathol. 2014, 44, 233–241. [Google Scholar] [CrossRef]
- Mahyudin, M.M.; Foster, G.D.; Bailey, A.M. Optimising Agrobacterium-mediated transformation of Corynespora cassiicola to deliver DsRed. J. Rubber Res. 2020, 23, 139–149. [Google Scholar] [CrossRef]
- Rodríguez-Pires, S.; Espeso, E.A.; Baró-Montel, N.; Torres, R.; Melgarejo, P.; De Cal, A. Labeling of Monilinia fructicola with GFP and its validation for studies on host-pathogen interactions in stone and pome fruit. Genes 2019, 10, 1033. [Google Scholar] [CrossRef] [PubMed]
- McDougal, R.; Yang, S.Y.; Schwelm, A.; Stewart, A.; Bradshaw, R. A novel GFP-based approach for screening biocontrol microorganisms in vitro against Dothistroma septosporum. J. Microbiol. Methods 2011, 87, 32–37. [Google Scholar] [CrossRef] [PubMed]
- Zhou, Y.H.; Lu, D.D.; Joseph, R.; Li, T.; Keyhani, N.O. High efficiency transformation and mutant screening of the laurel wilt pathogen, Raffaelea lauricola. Appl. Microbiol. Biotechnol. 2020, 104, 7331–7343. [Google Scholar] [CrossRef]
- Lafon, A.; Han, K.H.; Seo, J.A.; Yu, J.H.; d’Enfert, C. G-protein and cAMP-mediated signaling in aspergilli: A genomic perspective. Fungal Genet. Biol. 2006, 43, 490–502. [Google Scholar] [CrossRef] [PubMed]
- Li, L.; Wright, S.J.; Krystofova, S.; Park, G.; Borkovich, K.A. Heterotrimeric G-protein signaling in filamentous fungi. Annu. Rev. Microbiol. 2007, 61, 423–452. [Google Scholar] [CrossRef]
- Hicks, J.K.; Yu, J.H.; Keller, N.P.; Adams, T.H. Aspergillus sporulation and mycotoxin production both require inactivation of the FadA G alpha protein-dependent signaling pathway. EMBO J. 1997, 16, 4916–4923. [Google Scholar] [CrossRef]
- Adams, T.H.; Yu, J.H. Coordinate control of secondary metabolite production and asexual sporulation in Aspergillus nidulans. Curr. Opin. Microbiol. 1998, 1, 674–677. [Google Scholar] [CrossRef]
- Yu, J.H.; Rosén, S.; Adams, T.H. Extragenic suppressors of loss-of-function mutations in the Aspergillus FlbA regulator of G-protein signaling domain protein. Genetics 1999, 151, 97–105. [Google Scholar] [CrossRef]
- Li, J.X.; Hong, N.; Peng, B.; Wu, H.J.; Gu, Q.S. Transformation of Corynespora cassiicola by Agrobacterium tumefaciens. Fungal Biol. 2019, 123, 669–675. [Google Scholar] [CrossRef]
- Zhong, S.; Leng, Y.; Bolton, M.D. Construction of hairpin RNA-expressing vectors for RNA-mediated gene silencing in fungi. Methods Mol. Biol. 2012, 835, 623–633. [Google Scholar] [CrossRef]
- Livak, K.J.; Schmittgen, T.D. Analysis of relative gene expression data using real-time quantitative PCR and the 2(-Delta Delta C(T)) Method. Methods 2001, 25, 402–408. [Google Scholar] [CrossRef] [PubMed]
- Pham, T.; Chen, H.; Yu, J.M.; Dai, L.L.; Zhang, R.R.; Vu, T.Q. The differential effects of the blue-stain fungus Leptographium qinlingensis on monoterpenes and sesquiterpenes in the stem of Chinese white pine (Pinus armandi) saplings. Forests 2014, 5, 2730–2749. [Google Scholar] [CrossRef]

| Ascomycetes Fungi | Host Tree | Sensitivity to Hygromycin B |
|---|---|---|
| L. qinlingensis | P. armandii | 50 μg/mL |
| Neonectria galligena | Broad-leaved tree species | 50 μg/mL [56] |
| Ophiostoma piceae | Coniferous trees | 250 μg/mL [57] |
| Ophiostoma ulmi | Elm | 200 μg/mL [58] |
| Valsa mali var. mali (Vmm) | Apple tree | 60 μg/mL [59] |
| Sphaerulina musiva | Populus trichocarpa | 50 μg/mL [60] |
| Corynespora cassiicola | Hevea brasiliensis | 100 μg/mL [61] |
| Monilinia fructicola | Stone and pome fruit | 100 μg/mL [62] |
| Dothistroma septosporum | Coniferous trees | 100–200 μg/mL [63] |
| Raffaelea lauricola | Persea palustris and Persea americana | 110 μg/mL [64] |
| Primer Name | Sequences (5′→3′) | Purpose |
|---|---|---|
| P1 | catcgataccgtcgaccGCAGCGAGGATATTTCCAAGAagcttgctggaggatac | Construction of silencing vectors |
| P2 | acgttaagtggatccggGCAGCGAGGATATTTCCAAGAgtaccacaggccttagca | |
| Hyg-F | ATGAAAAAGCCTGAACTCAC | Confirm transformants |
| Hyg-R | GGTCGGCATCTACTCTATTC | |
| Test-F | AGGAACGAGGACATTATT | Confirm transformants |
| Test-R | GCTGACATCGACACCAAC | |
| FlbA-F | GCTATGATCGACACCCTGAAG | qPCR |
| FlbA-R | GTAGTTTCTCAGCGTATGGTCG | |
| EF1-F | CCGCTGGTACGGGTGAGTT | qPCR |
| EF1-R | CTTGGTGGTGTCCATCTTGTT |
Disclaimer/Publisher’s Note: The statements, opinions and data contained in all publications are solely those of the individual author(s) and contributor(s) and not of MDPI and/or the editor(s). MDPI and/or the editor(s) disclaim responsibility for any injury to people or property resulting from any ideas, methods, instructions or products referred to in the content. |
© 2023 by the authors. Licensee MDPI, Basel, Switzerland. This article is an open access article distributed under the terms and conditions of the Creative Commons Attribution (CC BY) license (https://creativecommons.org/licenses/by/4.0/).
Share and Cite
Gan, T.; An, H.; Tang, M.; Chen, H. Establishment of RNA Interference Genetic Transformation System and Functional Analysis of FlbA Gene in Leptographium qinlingensis. Int. J. Mol. Sci. 2023, 24, 13009. https://doi.org/10.3390/ijms241613009
Gan T, An H, Tang M, Chen H. Establishment of RNA Interference Genetic Transformation System and Functional Analysis of FlbA Gene in Leptographium qinlingensis. International Journal of Molecular Sciences. 2023; 24(16):13009. https://doi.org/10.3390/ijms241613009
Chicago/Turabian StyleGan, Tian, Huanli An, Ming Tang, and Hui Chen. 2023. "Establishment of RNA Interference Genetic Transformation System and Functional Analysis of FlbA Gene in Leptographium qinlingensis" International Journal of Molecular Sciences 24, no. 16: 13009. https://doi.org/10.3390/ijms241613009
APA StyleGan, T., An, H., Tang, M., & Chen, H. (2023). Establishment of RNA Interference Genetic Transformation System and Functional Analysis of FlbA Gene in Leptographium qinlingensis. International Journal of Molecular Sciences, 24(16), 13009. https://doi.org/10.3390/ijms241613009

